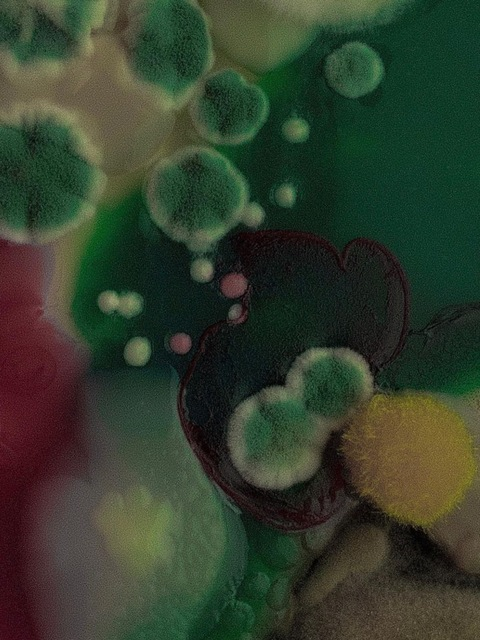
Header of eimidori

About eimidori
eimidori OnlyFans profile was leaked on 2022-05-18 00:00:00 by anonymous. There are 49 Photos and 32 Videos from the official eimidori OnlyFans profile.
Instead of paying money to OnlyFans and eimidori creator you get fresh nude content for free on our site.
What are places where @eimidori images has been leaked to?
You can download eimidori dropbox leaks. We also have mega.co.nz eimidori leaks containing videos and images. This eimidori OnlyFans user has made it easy to download free images and videos leaked on dropbox, mega.co.nz and Google Drive. eimidori is a really hot OnlyFans model and we are proud to say we have got the leaked videos and images of eimidori.
How many photos, videos and post does eimidori have leaked?
𝐸𝑖𝑚𝑖𝑖🌿, also known as @eimidori , has photos leaked, videos leaked and 81 posts leaked.
How can I get @eimidori OnlyFans leaks for free?
You just found them! You don't need to go anywhere else. You can find Download Link below and you will get access to leaked photos and (81 MB) leaked videos of @eimidori in a few minutes.
Is this @eimidori OnlyFans leaks safe to use?
Yes, it is! It's because we don’t host any leaks on our servers. We provide you an access to a third party websites. You can view all leaks by clicking the button "View all leaks".
What are the categories that best describe eimidori?
The categories that best describe 𝐸𝑖𝑚𝑖𝑖🌿 (@eimidori) OnlyFans are Teen, Amateur, Famous, Horney and Young.- eimidori OnlyFans Leaked (49 Photos and 32 Videos)
- New @eimidori leaked Onlyfans content for free
- eimidori (𝐸𝑖𝑚𝑖𝑖🌿) free OnlyFans Leaked Videos and Pictures
- Free access to (eimidori) Leak OnlyFans
- Download eimidori OnlyFans videos and photos for free
- View eimidori OnlyFans content for free
- Onlyfans leaks eimidori
- eimidori (𝐸𝑖𝑚𝑖𝑖🌿) free OnlyFans Leaked Videos and Pictures
- eimidori OnlyFans Leaked
- Onlyfans free eimidori
- 𝐸𝑖𝑚𝑖𝑖🌿 (eimidori) Leak OnlyFans
- eimidori all leaked videos
- eimidori free download onlyfans
- eimidori free download
- eimidori zip download
- eimidori videos leaked download
- eimidori leaks videos
- eimidori onlyfans leaked
- eimidori mega.co.nz download
- eimidori reddit download
- eimidori 4chan download
- eimidori google drive download
- eimidori chaturbate
- eimidori leaked images and videos